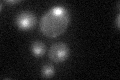

View description
MADS-box transcription factor, component of the protein kinase C-mediated MAP kinase pathway involved in the maintenance of cell integrity; phosphorylated and activated by the MAP-kinase Slt2p
Localization:
Intensity:
Fold change:
Significance:
-
C’ GFP library in SD
nucleus23.79 -
N' NOP1pr-GFP in SD

nucleus27.6838 -
N' TEF2pr-mCherry in SD

nucleus18.5317 -
N' NATIVEpr-GFP in SD

nucleus21.6928 -
N' TEF2pr-VC and Cyto-VN in SD

#N/A0 -
C’ GFP library in SD+DTT

nucleus28.151.18No -
C’ GFP library in SD+H2O2

nucleus25.561.07No -
C’ GFP library in Starvation Media

nucleus20.370.85No -
C’ GFP library on the background of Pup2-DaMP

nucleus -
C’ GFP library on the background of CCT mutant

nucleus22.47950.944323No
